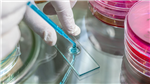

Address
Milltown House,
Milltown Industrial Estate
Milltown Industrial Estate
Warrenpoint
County Down
BT34 3FN
About Enviro Fire Water and Air Limited
At Enviro FWA, we specialise in delivering sustainable energy solutions & ensuring comprehensive building compliance for businesses across Northern Ireland. With a focus on simplicity, safety, and innovation, we empower our clients to adopt greener practices while maintaining operational efficiency.
Our Core Services
Air Conditioning & Refrigeration Installation & Maintenance
- Expert climate control solutions for consistent, year-round comfort.
- Routine maintenance and F-Gas compliance to optimise energy efficiency and safety.
Kitchen Duct Cleaning (TR19 Compliant)
- Specialist kitchen duct cleaning to meet insurance requirements.
- Essential for preventing fire hazards and maintaining a safe environment.
Kitchen Extraction Fan Replacement & Repair
- Avoid downtime and loss of earnings with efficient extraction fan solutions.
- 24/7 emergency callout services to keep your business running.
Legionella Management Services
- Comprehensive management & Risk Assessments , including routine checks, system maintenance, and temperature monitoring.
- Compliance with stringent safety standards to mitigate bacterial risks.
Solar PV Solutions
- Tailored solar panel systems to reduce energy bills and lower carbon emissions.
- Property assessments and bespoke designs for optimal energy performance.
Air Source Heat Pumps
- Efficient renewable heating solutions, even in colder climates.
- Improves EPC ratings and cuts carbon emissions, saving costs.
Ventilation Hygiene Cleaning
- Expert duct cleaning to ensure clean air and safety.
- Prevents ,fire hazards, and ensures Clean Air full compliance.
Fire Damper Testing
- Maintenance programs aligned with **BS 999 standards** to enhance fire safety.
- Regular testing to prevent fire spread and ensure compliance.
Planned & Reactive Maintenance
- Reliable **24/7 installation, repair, and maintenance services** for critical systems.
- Maintains operational compliance and minimizes downtime.
Portable Appliance Testing (PAT)
- Thorough electrical safety checks for businesses across Northern Ireland.
- Ensures compliance and a safe working environment.
Why Choose Enviro FWA?
- Flexible Scheduling: Services designed to minimize disruptions to your operations.
- Customer-Centric Approach: Dedicated to building lasting client relationships through exceptional service.
- Decades of Expertise: Over 25 years of experience providing reliable, forward-thinking solutions.
Optimise Energy Efficiency & Compliance with Enviro FWA
We are your trusted partner for sustainable energy solutions and building compliance. Whether it’s air conditioning, solar energy, or ventilation hygiene, our tailored services ensure efficiency, safety, and sustainability.
Contact Enviro FWA today to take the next step toward a greener, safer, and more compliant future.